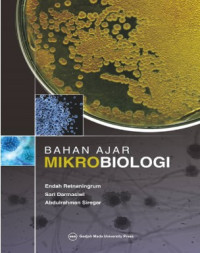
Image of Bahan Ajar Mikrobiologi

Detail Cantuman
Pencarian Spesifik
Text
Bahan Ajar Mikrobiologi
Buku ini disusun untuk membantu para mahasiswa S-1 di Fakultas Biologi UGM dalam memahami konsep dasar teoretis mengenai mikrobiologi dasar yang hingga saat ini buku ajar dan pustaka mengenai mikrobiologi dalam bahasa Indonesia masih sangat terbatas. Selain itu, buku ini diharapkan membantu mahasiswa memahami dan mempersiapkan diri dalam perkuliahan maupun melalui pustaka yang terkait (learning to know). Penulis berharap bahwa buku ajar ini dapat bermanfaat bagi keberhasilan mahasiswa dalam meningkatkan pemahaman akan hakikat studi keanekaragaman dunia mikrobia serta teknik yang digunakan dalam mempelajari mikrobiologi sebagai pengantar dalam mempelajari cabang ilmu mikrobiologi berikutnya, di bidang mikrobiologi industri, kesehatan, lingkungan, dan lain sebagainya.
Ketersediaan
| 2207400 | 660.634 Ret B | ITSI Library (R8) | Tersedia |
| 2210618 | 660.634 Ret B | ITSI Library (R8) | Tersedia |
| 2210619 | 660.634 Ret B | ITSI Library (R8) | Tersedia |
Informasi Detail
| Judul Seri |
-
|
|---|---|
| No. Panggil |
660.634 Ret B
|
| Penerbit | Gadjah Mada University Press : Yogyakarta., 2017 |
| Deskripsi Fisik |
xvi, 152 hlm., 23 cm
|
| Bahasa |
Indonesia
|
| ISBN/ISSN |
9786023861750
|
| Klasifikasi |
660.634
|
| Tipe Isi |
-
|
| Tipe Media |
-
|
|---|---|
| Tipe Pembawa |
-
|
| Edisi |
-
|
| Subjek | |
| Info Detail Spesifik |
-
|
| Pernyataan Tanggungjawab |
-
|
Versi lain/terkait
Tidak tersedia versi lain
Informasi
Akses Katalog Publik Daring - Gunakan fasilitas pencarian untuk mempercepat penemuan data katalog